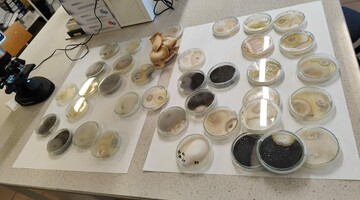

Dzień Ziemi 2026 za nami
Nasza moc, nasza planeta Dzień Ziemi 2026 na WIiŚ
Za nami dzień pełen wiedzy, emocji i inspirujących spotkań. Po raz kolejny Wydział Infrastruktury i Środowiska Politechniki Częstochowskiej wziął udział w międzynarodowych obchodach EarthDay2026, pokazując, że tegoroczne hasło „Nasza moc, nasza planeta” naprawdę ma znaczenie - bo siła do zmieniania świata na lepsze tkwi właśnie w nas.
Program wydarzenia obejmował dwa bloki:
- część wykładową
oraz - rotacyjne warsztaty tematyczne.
Podczas wydarzenia gościliśmy uczniów:
- II LO im. Romualda Traugutta w Częstochowie,
- Zespół Szkół Technicznych w Częstochowie,
- I LO im. Juliusza Słowackiego, w Częstochowie,
- Liceum Ogólnokształcącego im.Marii Skłodowskiej-Curie w Koziegłowach,
- Zespołu Szkół nr 1 im. Eugeniusza Kwiatkowskiego w Myszkowie,
- Soward Academy - Międzynarodowa Szkoła Podstawowa w Częstochowie
Uczestnicy wysłuchali dwóch bardzo ciekawych wystąpień: pana Adama Chudzika z Nadleśnictwa Gidle, PGL Lasy Państwowe, który opowiedział o roli człowieka w ochronie lasu przed zagrożeniami oraz pana Huberta Pietrzaka z Częstochowskiego Alarmu Smogowego, który nie tylko poruszył ważny temat odpadów, ale też zaprosił wszystkich do udziału w akcji JurabezPlastiku 2026, wspólnej akcji z Wydziałem Infrastruktury i Środowiska sprzątania malowniczych zakątków Jury, która odbędzie się już w najbliższą niedzielę.
W programie znalazł się również konkurs ekologiczny, który wzbudził ogromne emocje - niemal do ostatniej chwili nie było wiadomo, kto sięgnie po zwycięstwo.
Podczas warsztatów na młodzież czekał prawdziwy ekologiczny maraton pełen praktycznych działań, odkryć i kreatywnych wyzwań. Dużym zainteresowaniem cieszyły się warsztaty „Zbuduj domki dla owadów”, podczas których powstały nowe schronienia dla pożytecznych owadów. Uczestnicy mogli także zajrzeć do fascynującego świata grzybów, obserwując pod mikroskopem przygotowane preparaty i odkrywając zaskakujące zależności oraz swoiste „wojny” pomiędzy różnymi gatunkami. Z kolei pod przewrotnym tytułem „Gleba pod lupą” kryły się ciekawe analizy fizykochemiczne, pokazujące, jak wiele można odczytać z pozornie zwyczajnej próbki ziemi.
Nie zabrakło także działań pokazujących, że ekologia zaczyna się od codziennych wyborów. Podczas warsztatów „Dbając o siebie, dbasz o Ziemię” uczestnicy poznawali tajniki tworzenia ekologicznych mydełek w fantazyjnych kształtach, przekonując się, że troska o siebie może iść w parze z troską o planetę.
Ogromną wartość miały również zajęcia poświęcone segregacji odpadów, które poprowadziło Centrum Usług Komunalnych, przybliżając młodzieży praktyczne zasady właściwego postępowania z odpadami. Warsztaty „Świat recyklingu” otworzyły z kolei drzwi do świata upcyklingu i pokazały, jak z pozornie niepotrzebnych rzeczy stworzyć coś wartościowego, użytecznego i po prostu fajnego.
Współorganizatorami wydarzenia, a zarazem prowadzącymi część warsztatów, byli studenci dwóch kół naukowych działających na naszym Wydziale Koło Naukowe EkoPraktyczni oraz #EnviBioTeam. To dzięki ich zaangażowaniu Dzień Ziemi po raz kolejny stał się nie tylko świętem ekologii, ale też przestrzenią do rozmowy, działania i budowania świadomości środowiskowej wśród młodzieży.
Dziękujemy wszystkim prelegentom, prowadzącym, partnerom i uczestnikom za obecność, energię i wspólne tworzenie tego wyjątkowego dnia. Tegoroczny Dzień Ziemi pokazał bardzo wyraźnie, że nasza moc naprawdę ma znaczenie - a kiedy łączymy wiedzę, zaangażowanie i współpracę, możemy realnie działać dla naszej planety.